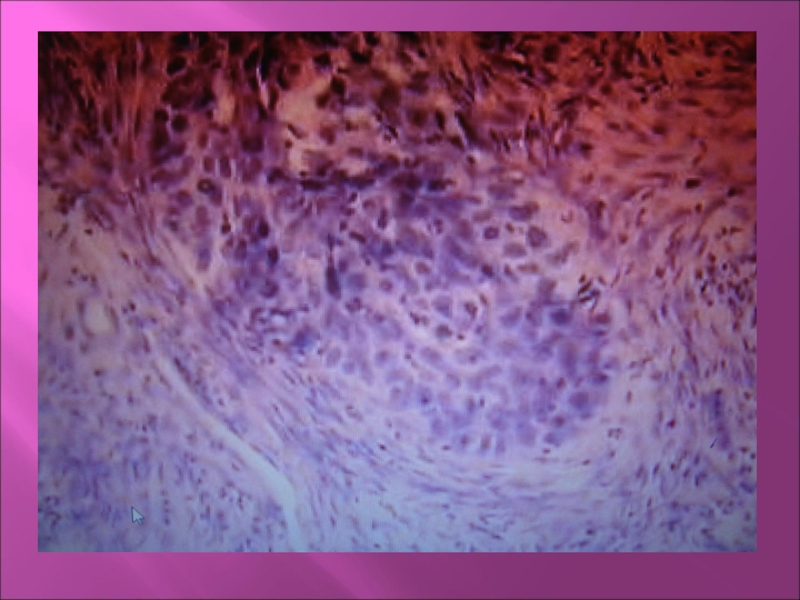

Разделы презентаций
- Разное
- Английский язык
- Астрономия
- Алгебра
- Биология
- География
- Геометрия
- Детские презентации
- Информатика
- История
- Литература
- Математика
- Медицина
- Менеджмент
- Музыка
- МХК
- Немецкий язык
- ОБЖ
- Обществознание
- Окружающий мир
- Педагогика
- Русский язык
- Технология
- Физика
- Философия
- Химия
- Шаблоны, картинки для презентаций
- Экология
- Экономика
- Юриспруденция
заболевания слюнных желез
Содержание
- 1. заболевания слюнных желез
- 2. Слайд 2
- 3. Болезни слюнных желез
- 4. Травматические поврежденияПричины: огнестрельные ранения, бытовые, спортивные и
- 5. КсеростомияСухость полости рта –у большинства больных идиопатическое
- 6. Синдромы с поражением слюнных желез.1. Синдром Шегрена-
- 7. 2. Синдром Микулича- безболезненное увеличение слезных и
- 8. Синдром Хеерофордта-саркоидозИзолированное поражение слюнных желез или сочетание
- 9. Инфекционные заболеванияВирусные инфекции.Эпидемический паротитПоражение околоушных слюнных желез.
- 10. Слайд 10
- 11. Бактериальный инфекции Острый гнойный сиаладенитВоспаление слюнной железы.Может
- 12. Хронический сиаладенит1-начальная стадия. Макроскопически: железа сохраняет свое
- 13. 2- клинически выраженная стадия.Определяются увеличенные неправильной формы
- 14. Слайд 14
- 15. Слайд 15
- 16. Слюнокаменная болезньОбразование в железе или в ее
- 17. Патологическая анатомия1. Начальная стадия- перидуктальные и периваскулярные
- 18. 3- Поздняя стадия. Полная атрофия паренхимы, замещение
- 19. Слайд 19
- 20. Кисты желез.Возникают чаще в малых железах.Причина –
- 21. Слайд 21
- 22. Слайд 22
- 23. ОпухолиСоставляют 6 % всех опухолей.Развиваются и в
- 24. Слайд 24
- 25. Плеоформная аденомаСамая частая опухоль (50%).Локализуется чаще в
- 26. Слайд 26
- 27. Слайд 27
- 28. Слайд 28
- 29. Слайд 29
- 30. Мономорфная аденомаРедкая, доброкачественная. (1-3%)Чаще локализуется в околоушной
- 31. Слайд 31
- 32. Аденолимфома.Чаще встречается в околоушной железе пожилых мужчин.Макроскопически:
- 33. Слайд 33
- 34. Слайд 34
- 35. Оксифильная аденомаДоброкачественная опухоль, состоит из крупных клеток
- 36. Мукоэпидермоидная опухоль.Чаще у женщин любого возраста в
- 37. Слайд 37
- 38. Слайд 38
- 39. Ацинозноклеточная опухольОпухоль хорошо ограничена, но может иметь
- 40. Слайд 40
- 41. КарциномыВиды карцином:1. Цистаденоидная2. Аденокарцинома3. Плоскоклеточный рак4. Недифференцированный рак5. Карцинома в полиморфной аденоме.
- 42. Слайд 42
- 43. Карциномы слюнных желез. Чаще встречается в малых
- 44. Слайд 44
- 45. Цистаденоидная карцинома (цилиндрома)Чаще поражает малые железы. Макроскопически:
- 46. Слайд 46
- 47. Слайд 47
- 48. Спасибо за внимание!Спасибо за внимание!
- 49. Скачать презентанцию
Болезни слюнных желез
Слайды и текст этой презентации
Слайд 4Травматические повреждения
Причины: огнестрельные ранения, бытовые, спортивные и производственные травмы.
Чаще всего
это последствия операцонной травмы.
всего закрытые в виде ушибов, кровоизлияний и гематом.Слайд 5Ксеростомия
Сухость полости рта –у большинства больных идиопатическое заболевание, обусловлено нарушением
секреторной функции.
3 стадии:
1-начальная стадия. Жалоб нет. Периодически сухость во рту.
В секрете увеличенное количество клеток плоского и цилиндрического эпителия.2 стадия- постоянная сухость во рту. В слюне бокаловидные клетки.
3 стадия- появляются воспалительные изменения слизистой полости рта.
Слайд 6Синдромы с поражением слюнных желез.
1. Синдром Шегрена- поражение слюнных желез
в сочетании с системным заболеваниями соединительной ткани.
В поздней стадии характерно
выраженное замещение паренхимы слюнной железы лимфоидной тканью. Инфильтрат состоит из лимфоцитов, плазматических клеток, макрофагов. Сохранившийся ацинарный эпителий с дистрофическими и некротическими процессами. Слайд 72. Синдром Микулича- безболезненное увеличение слезных и всех слюнных желез,
не сопровождающееся нарушением их функции.
В слюнных железах выраженная лимфоидная инфильтрация.
Внутридольковые протки не определяются, сохраняются лишь междольковые протоки. Строма инфильтрированна лимфоцитами. В лимфотических узлах разрастание незрелой лимфоидной ткани.Слайд 8Синдром Хеерофордта-саркоидоз
Изолированное поражение слюнных желез или сочетание с поражением слезных
желез.
Гистологически: неравнометное замещение ацинусов крупными эпителиоидными клетками со светлой цитоплазмой.
Располагаются диффузно или формируют гранулемы с гигантскими многоядерными клетками.Слайд 9Инфекционные заболевания
Вирусные инфекции.
Эпидемический паротит
Поражение околоушных слюнных желез.
Микроскопически: вакуольная дистрофия
эпителия, некроз ацинусов, интерстициальной воспаление.
Цитомегаловирусная инфекция
Микроскопически:инфильтрация лимфоцитами, плазмоцитами и макрофагами.
Гигантоклеточный метаморфоз эпителиальных клеток.Слайд 11Бактериальный инфекции
Острый гнойный сиаладенит
Воспаление слюнной железы.
Может быть первичным и вторичным.
Может
вовлекаться одна или несколько желез.
Пути проникновения различны: стоматогенный лимфогенный, контактный.
Микроскопически:
очаги некроза, микроабсцессы, в выводных протоках гной.Исход-атрофия паренхимы и фиброз
Слайд 12Хронический сиаладенит
1-начальная стадия.
Макроскопически: железа сохраняет свое строение.
Микроскопически: очаговое
поражение внутридольковых протоков. Просвет их расширен, эпителий с дистрофическими и
местами с пролиферативными изменениями. Незначительный отек и очаговая лимфо-плазмоклеточная инфильтрация соединительной ткани.Слайд 132- клинически выраженная стадия.
Определяются увеличенные неправильной формы дольки.
Микроскопически: дистрофия и
пролиферация эпителия внутридольковых протоков. Расширение их просвета с десквамацией эпителия.
Увеличение соединительной ткани. Разрушение секреторного отдела железы.3-поздняя стадия.
Значительный фиброз железы, образование кист.
В соединительной ткани круглоклеточные инфильтраты.
Слайд 16Слюнокаменная болезнь
Образование в железе или в ее протоках конкрементов.
Чаще поражается
подчелюстная железа, никогда не поражается подъязычная железа.
Болеют чаще мужчины среднего
возраста.Образование камней связывают с дискинезией протоков, воспалением, застоем и ощелачиванием.
Слайд 17Патологическая анатомия
1. Начальная стадия- перидуктальные и периваскулярные лимфогистиомоноцитарные инфильтраты, отек,
разрыхление соединительной ткани, полнокровие. Ацинусы сохранены, протоки несколько расширены.
2. Клинически
выраженная стадия-склероз и гиалиноз стромы, выводные протоки окружены фиброзной тканью, деформированы, атрофия концевых отделов ацинусов.Слайд 183- Поздняя стадия.
Полная атрофия паренхимы, замещение ее соединительной тканью.
Диффузная лимфогистиоцитарная инфильтрация. Просветы выводных протоков резко деформированы. Вокруг камня
формируется грануляционная ткань с лейкоцитами и гигантскими клетками инородных тел.Слайд 20Кисты желез.
Возникают чаще в малых железах.
Причина – обтурация выводного протока
(травма, воспаление, склероз).
Различают: кисты ретенционные (истинные) и травматические (экстравазатные).
Киста имеет
четкие границы, гладкую поверхность, при пальпации флюктуирует.Слайд 23Опухоли
Составляют 6 % всех опухолей.
Развиваются и в больших и в
малых железах.
Могут развиваться из секреторных отделов и из протоков. Чаще
встречаются опухоли слюнных желез эпителиального генеза.Встречаются формы ( по данным ВОЗ):
1. Аденомы
2. Мукоэпидермоидная опухоль
3. Ациноклеточная опухоль
4. Карциномы.
Слайд 25Плеоформная аденома
Самая частая опухоль (50%).
Локализуется чаще в околоушной железе.
Чаще у
женщин, обычно старше 40 лет.
Растет медленно.
Макро: Узел округлой формы, бугристый,
плотный или эластичный, размер 5-6 см., окружен капсулой. На разрезе ткань белая с хрящевидными и слизистыми участками, кистами.Микро: разнообразна, эпителиальные клетки имеют структуру протоков, солидных полей, гнезд. Есть скопления вытянутых клеток, полей мукоидного, миксоидного и хондроидного вещества.
Слайд 30Мономорфная аденома
Редкая, доброкачественная. (1-3%)
Чаще локализуется в околоушной железе.
Однородный клеточный состав,
отсутствие мезенхимального компонента.
Макроскопически: Инкапсулированный узел, округлый, 1-2 см, плотный, беловато-розовый
(иногда коричневый).Микроскопически: Железистые кистозные образования, солидные поля эпителиальных клеток.
Слайд 32Аденолимфома.
Чаще встречается в околоушной железе пожилых мужчин.
Макроскопически: Четко ограниченный инкапсулированный
узел, до 5 см., серовато-белый, дольчатый, с кистами.
Микроскопически: Призматический эпителий
с резко эозинофильной цитоплазмой располагается в два ряда, формирует сосочковые выросты. Строма инфильтрирована лимфоцитами.Слайд 35Оксифильная аденома
Доброкачественная опухоль, состоит из крупных клеток с зернистой эозинофильной
цитоплазмой и небольшим ядром.
Опухоль имеет капсулу, на разрезе коричневого цвета.
Чаще
болеют женщины старше 60 лет. Слайд 36Мукоэпидермоидная опухоль.
Чаще у женщин любого возраста в околоушной слюной железе.
Макроскопически: не всегда четко ограничена, округлой или неправильной формы, может
состоять из нескольких узлов, серовато-белая, плотная, есть кисты.Микроскопически: различное сочетание клеток эпидермоидного типа, образующих солидные структуры. Среди них слизеобразующие клетки с базофильной цитоплазмой. Хорошо выражена строма.
Слайд 39Ацинозноклеточная опухоль
Опухоль хорошо ограничена, но может иметь инвазивный рост.
Может давать
метастазы при отсутствии признаков злокачественности.
Макроскопически: узел с дольчатой, зернистой, слизистой
поверхностью.Микроскопически: клетки опухоли схожи с серозными клетками слюнных желез, цитоплазма базофильная, мелкозернистая. Клетки образуют солидные поля и тяжи.
Слайд 41Карциномы
Виды карцином:
1. Цистаденоидная
2. Аденокарцинома
3. Плоскоклеточный рак
4. Недифференцированный рак
5. Карцинома в
полиморфной аденоме.
Слайд 43Карциномы слюнных желез.
Чаще встречается в малых железах твердого и мягкого
неба.
Преимущественно у лиц 40-60 лет.
Макроскопически: плотный, небольшой сероватый узел,
без четких границ.Микроскопически: мелкие клетки кубической формы, с гиперхромным ядром, формирующие трабекулы и солидные структуры. Между клетками базофильное или оксифильное вещество, образующее столбики и цилиндры.
Рост опухоли инвазивный.